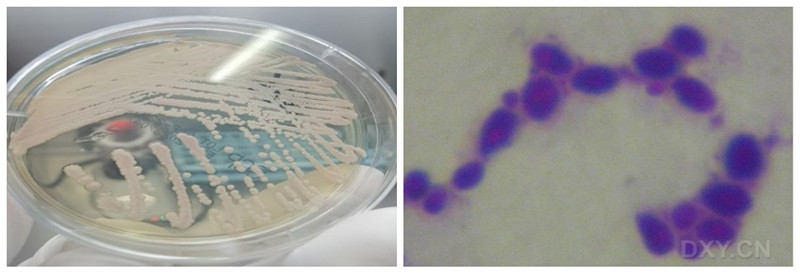

大家知道吗?在我们肉眼看到的世界里,其实是热闹非凡的,无数小家伙在呼吸,吃饭、睡觉、嬉戏·····没错它们就是微生物。

微生物到底是何方圣神?
微生物,它们存在于自然界的一大群体,体型微小,结构简单,肉眼看不见,必须借助光学显微镜或电子显微镜,放大数百倍至数万倍,才能观察到的微小微生物,但有些微生物可以用肉眼观察到,如食用蘑菇、银耳等。下面我们来了解一下几种常见的微生物:细菌、真菌、病毒。
1.细菌
细菌是一类细胞细短,结构简单,胞壁坚韧,多以二分裂方式繁殖和水生性强的原核生物。分布在温暖,潮湿和富含有机质的地方,具有细胞膜、细胞壁、细胞质和核质。单个细菌用肉眼是看不见的,当单个或少数细菌在固体培养基上大量繁殖时,便会形成一个肉眼可见的,具有一定形态结构的子细胞群落。菌落是菌种鉴定重要的依据,不同种类的细菌菌落的大小,形状光泽度颜色硬度透明度都不同。
细菌菌落 球菌 杆菌

细菌的特点:它们个体小,面积大,分布广,种类多,肉眼不可见,而且,适应性强,异变异,生长旺,繁殖快,他们有着惊人的繁殖速度,大多数可以几十分钟繁殖一代,他们广泛存在于水、空气、衣服、地面,废水等等。细菌菌落的主要特征:湿润、粘稠、光滑等。
2.那什么又是真菌呢?
真菌是一类具有典型的细胞核和完整的细胞器,无根、茎、没有叶绿素。细胞壁的主要成分为几丁质或纤维素或两者兼有。真菌在自然界分布广泛,种类繁多,大多对人类有利,如用于酿酒,制酱、生产抗生素等。包含霉菌、酵母、蕈菌以及其他人类所熟知的菌菇类。

我们微生物实验室常见的真菌包括霉菌和酵母菌,霉菌是菌丝体比较发达而又没有较大子实体的一部分真菌的俗称。它可以迅速的蔓延,有的在2~3天内能布满几英寸。与食品卫生关系密切的霉菌主要有曲霉菌属,主要寄生或腐生方式生存,所以会使食品,转变为有毒物质,有的还会产生毒素,也就是霉菌毒素,例如常见黄曲霉毒素。

而酵母菌菌落的主要特征,与细菌相似,但一般较大,酵母菌与我们生活密不可分,已在食品、饮料、饲料等工业领域得到广泛应用。但有些酵母菌具有危害性能引起皮肤、呼吸道、消化道、泌尿道疾病(例如:白色假丝酵母菌、新生隐球菌等)
3.病毒
病毒是一类由核酸和蛋白质等少数几种成分组成的“非细胞生物”, 它的生存必须依赖于活细胞。病毒广泛存在自然界,一旦侵入人体,动物、植物、真菌及细菌体内可引起宿主生活的改变,由微生物感染疾病中,病毒疾病占75%。

有些病毒性疾病病情严重、死亡率高(如艾滋病毒、狂犬病毒),有些病毒传染性强,存活时间长,如普通的流感病毒,在手上也能存活5分钟,禽流感病毒,在衣服表面能停留8小时,sars病毒可以在光滑的物体表面存活5天,病毒性疾病不仅传染性强、流行广泛,而且缺乏特效治疗药物。
病毒主要是通过飞沫传播,当我们打出喷嚏,咳嗽后,飞沫接触到人体的黏膜,包括鼻腔、口腔、和嘴,病毒就会和受体结合从而感染。
总之无处不在的微生物与人类共同生存了数百万年,它们曾造福于人类,也给人类造成过毁灭性的灾难,始终保持着“亦敌亦友”的奇妙关系。人类对微生物的了解、探索任重而道远,那么对微生物的认识和研究同时,生物安全也极其重要。
什么是生物安全?
生物安全的概念有狭义和广义之分。狭义的生物安全是指防范现代生物技术的开发和应用所产生的负面影响,即对生物多样性、生态环境及人体健康可能造成的风险。广义的生物安全还包括重大新突发传染病、动植物疫情、外来生物入侵、生物遗传资源和人类遗传资源的流失、实验室生物安全、微生物耐药性、生物恐怖袭击、生物武器威胁等。
《中华人民共和国生物安全法》
一、实施时间
《中华人民共和国生物安全法》于2020年10月17日第十三届全国人大常委会第二十二次会议通过,自2021年4月15日起正式实施,共十章八十八条,聚焦生物安全领域主要风险,完善生物安全风险防控体制机制,着力提高国家生物安全治理能
二、立法意义为了维护国家安全,防范和应对生物安全风险,保障人民生命健康,保护生物资源和生态环境,促进生物技术健康发展,推动构建人类命运共同体,实现人与自然和谐共生。






图文来源
医学检验科:兰丽